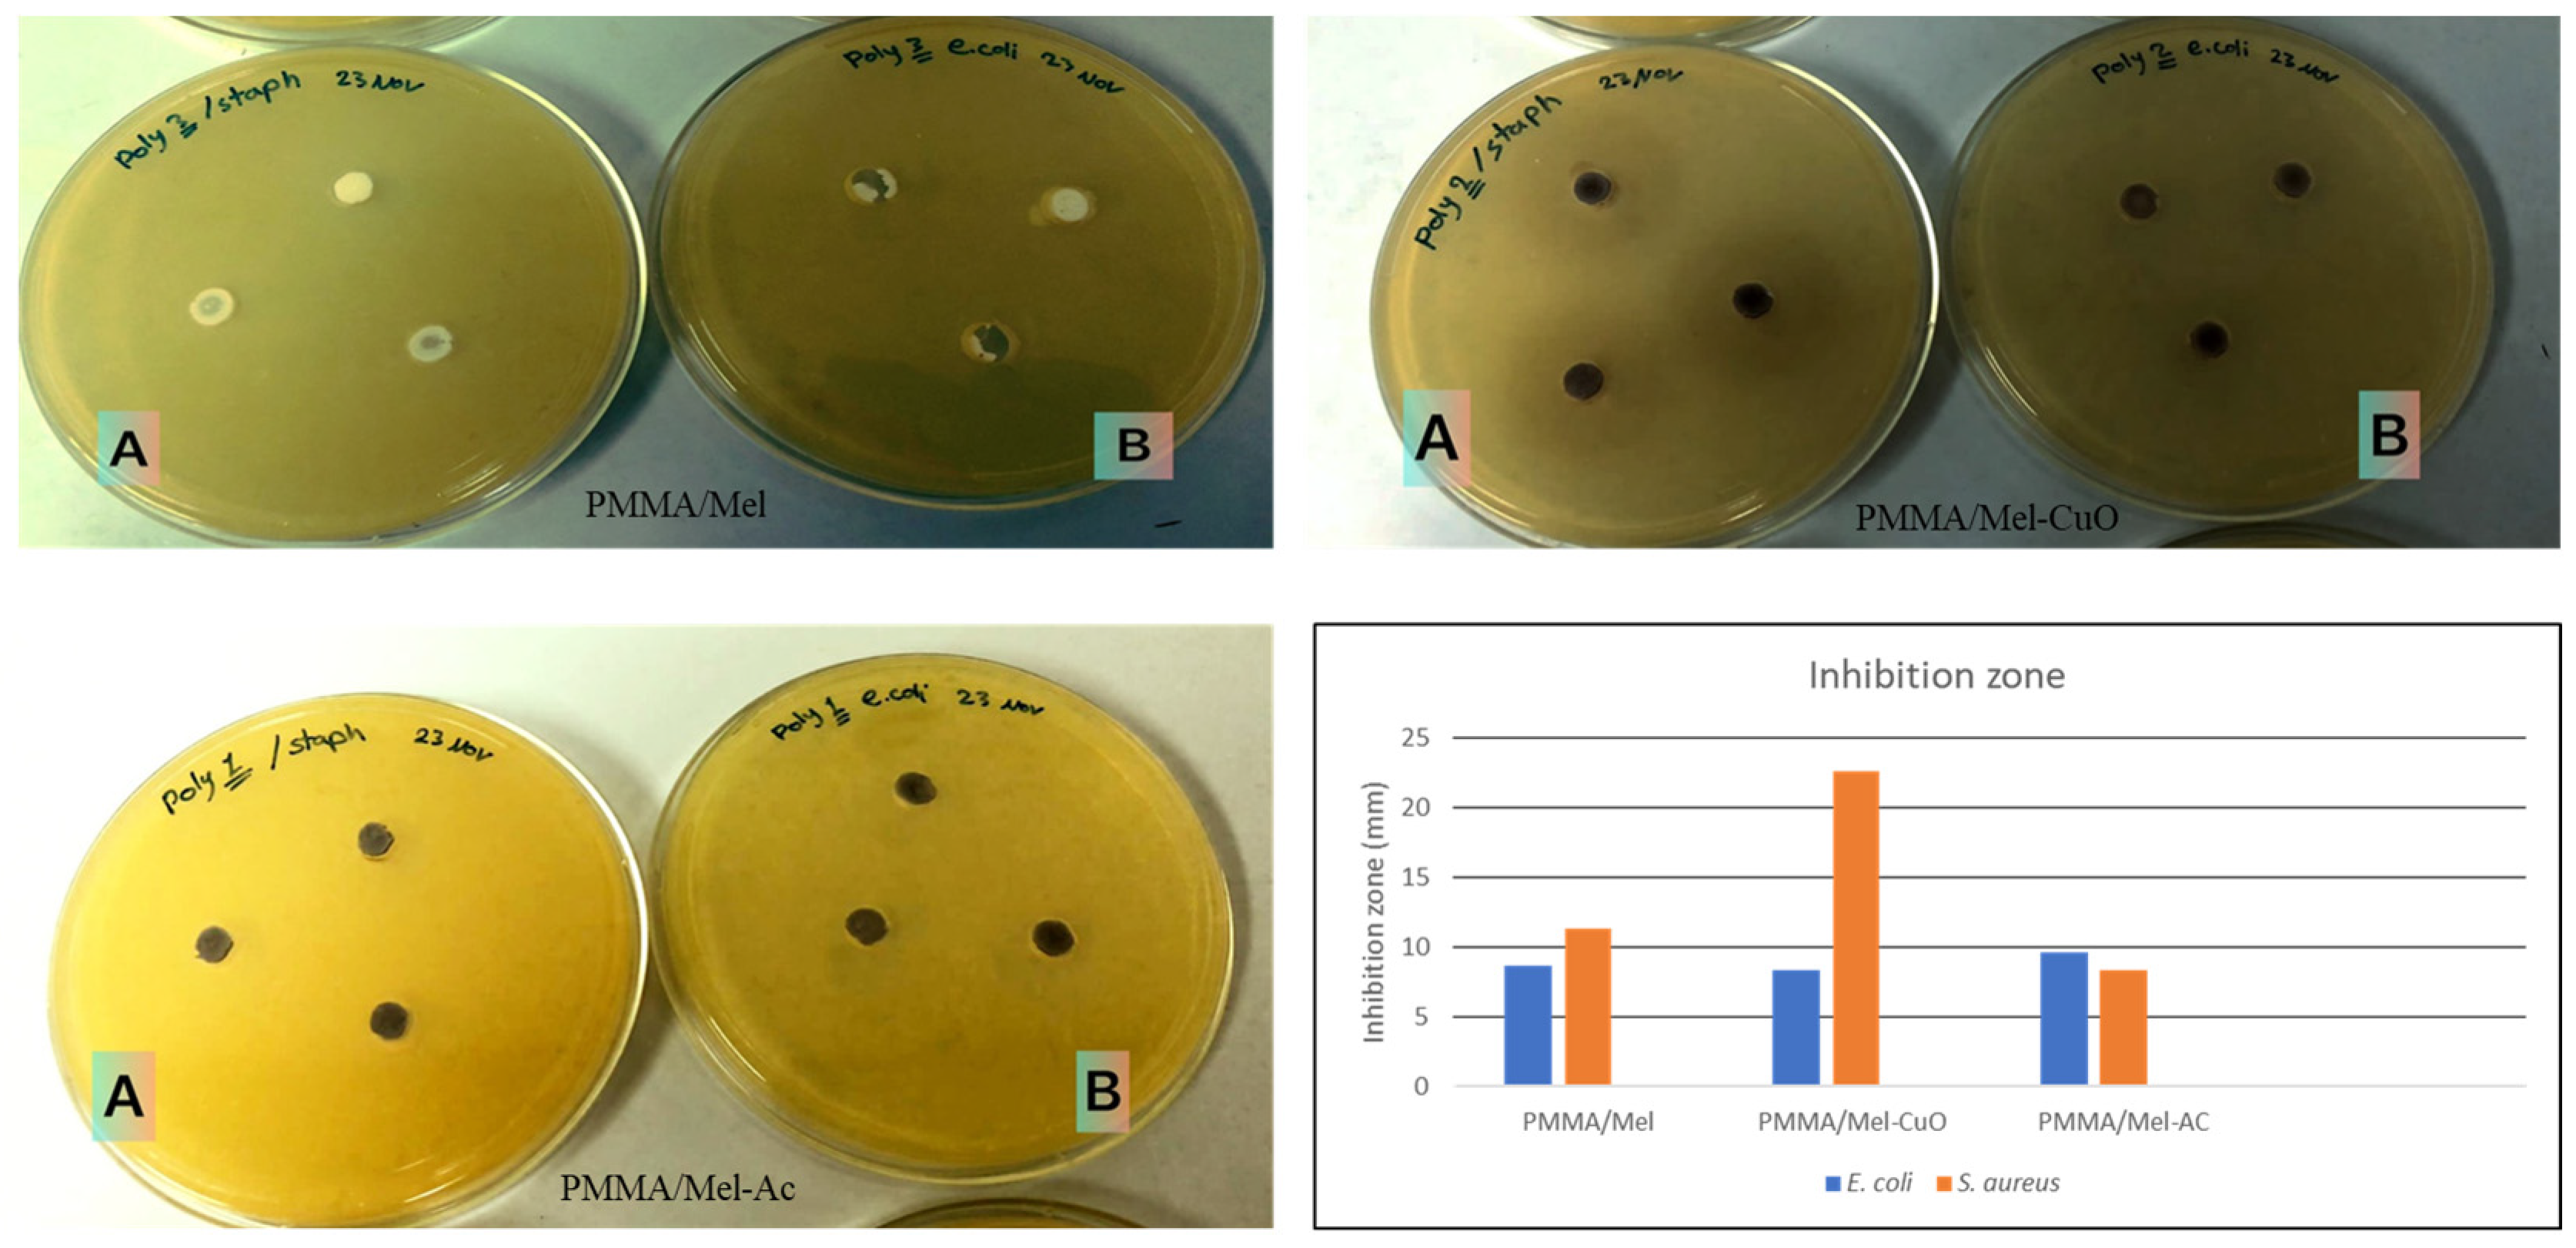
Polymers 17 00269 g005 Polymers 17 00269 g005
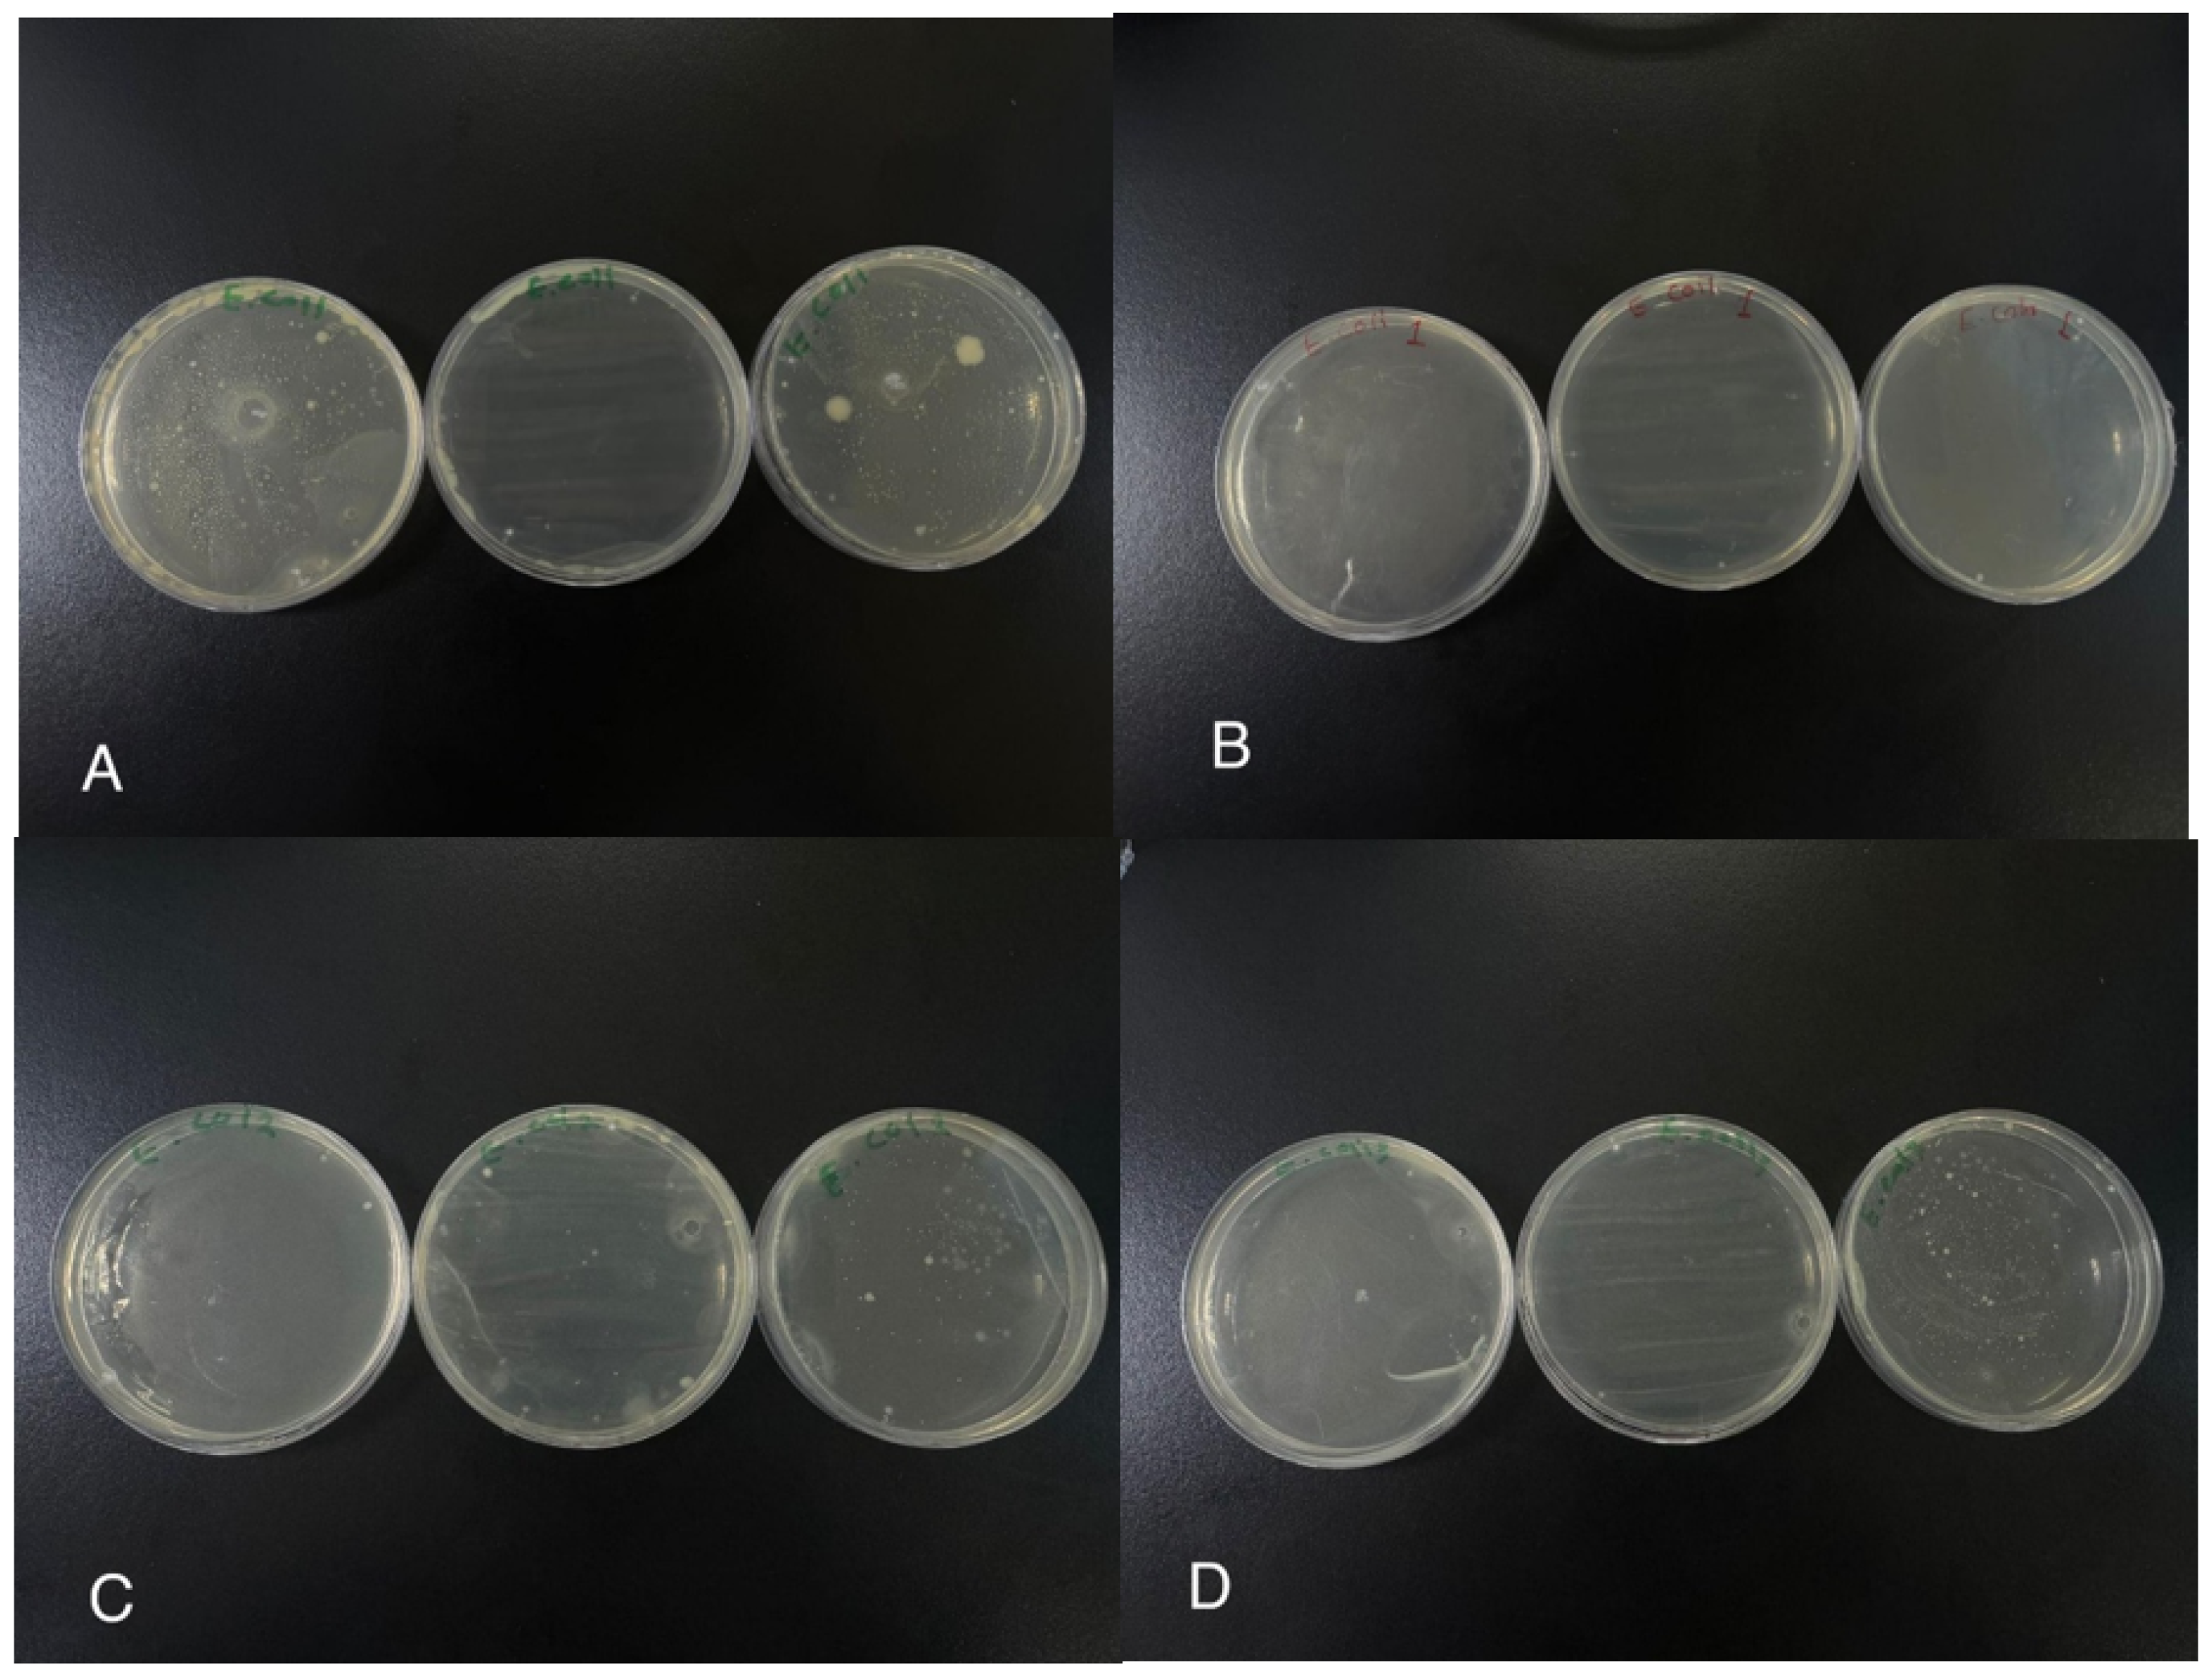
Polymers 17 00269 g007 Polymers 17 00269 g007

Cross-Linked Poly(methyl methacrylate) Nanocomposites’ Synthesis, Characterization, and Antibacterial Effects
Abstract
1. Introduction
2. Experimental Section
2.1. Materials
2.2. Instrumentation
2.3. Synthesis of PMMA/Mel, PMMA/Mel-CuO, and PMMA/Mel-AC Nanocomposites
2.4. The Antibacterial Activities of PMMA/Mel-CuO and PMMA/Mel-AC Nanocomposites and PMMA/Mel
2.4.1. Preparation of the Inoculums
2.4.2. Determination of the Antibacterial Activity of (PMMA) Polymers Using the Agar-Well Diffusion Method
2.4.3. Antibiotics
2.4.4. Antibiotic Sensitivity Assay for Bacteria
2.4.5. Determination of the Antibacterial Activity of (PMMA) Polymers Using the Colony Count Method
3. Results and Discussion
3.1. Structural Investigation
3.2. Thermal Study
3.3. Morphological Investigation
3.4. Antibacterial Activity of Polymers Determined with the Agar-Well Diffusion Method
3.5. Antibiotic Sensitivity Assay of Pathogenic E. coli Strain
3.6. Antibacterial Activity of Polymers Determined with the Colony Count Method
4. Conclusions
Author Contributions
Funding
Data Availability Statement
Acknowledgments
Conflicts of Interest
References
- Lakshmi, S.; Avti, P.K.; Hegde, G. Activated carbon nanoparticles from biowaste as new generation antimicrobial agents: A review. Nanostructures Nano-Objects 2018, 16, 306–321. [Google Scholar] [CrossRef]
- Luksiene, Z. Nanoparticles and their potential application as antimicrobials in the food industry. In Food Preservation; Academic Press: Cambridge, MA, USA, 2017; pp. 567–601. [Google Scholar] [CrossRef]
- Moellering, R.C. Introduction: Problems with Antimicrobial Resistance in Gram-Positive Cocci. Clin. Infect. Dis. 1998, 26, 1177–1178. [Google Scholar] [CrossRef] [PubMed][Green Version]
- Wen, J.; Jiang, F.; Yeh, C.K.; Sun, Y. Controlling fungal biofilms with functional drug delivery denture biomaterials. Colloids Surf. B Biointerfaces 2016, 140, 19–27. [Google Scholar] [CrossRef] [PubMed]
- Matsuo, H.; Suenaga, H.; Takahashi, M.; Suzuki, O.; Sasaki, K.; Takahashi, N. Deterioration of polymethyl methacrylate dentures in the oral cavity. Dent. Mater. J. 2015, 34, 234–239. [Google Scholar] [CrossRef]
- Slane, J.; Vivanco, J.; Rose, W.; Ploeg, H.L.; Squire, M. Mechanical, material, and antimicrobial properties of acrylic bone cement impregnated with silver nanoparticles. Mater. Sci. Eng. 2015, 48, 188–196. [Google Scholar] [CrossRef]
- Rao, S.; Nandish, B.T.; Ginjupalli, K.; Jayaprakash, K. A review on poly (methyl methacrylate) denture base materials with antimicrobial properties. Trends Biomater. Artif. Organs. 2021, 35, 316–322. [Google Scholar]
- Neu, H.C. The Crisis in Antibiotic Resistance. Science 1992, 257, 1064–1073. [Google Scholar] [CrossRef]
- Salah, N.; Alfawzan, A.M.; Allafi, W.; Baghdadi, N.; Saeed, A.; Alshahrie, A.; Al-Shawafi, W.M.; Memic, A. Size-controlled, single-crystal CuO nanosheets and the resulting polyethylene–carbon nanotube nanocomposite as antimicrobial materials. Polym. Bull. 2021, 78, 261–281. [Google Scholar] [CrossRef]
- Taran, M.; Rad, M.; Alavi, M. Antibacterial activity of copper oxide (CuO) nanoparticles biosynthesized by bacillus sp. FU4: Optimization of experiment design. Pharm. Sci. 2017, 23, 198–206. [Google Scholar] [CrossRef]
- Mary, A.P.A.; Ansari, A.T.; Subramanian, R. Caffeine-mediated synthesis of CuO nanoparticles: Characterization, morphology changes, and bactericidal activity. Inorg. Nano-Metal Chem. 2020, 51, 174–181. [Google Scholar] [CrossRef]
- Sutradhar, P.; Saha, M.; Maiti, D. Microwave synthesis of copper oxide nanoparticles using tea leaf and coffee powder extracts and its antibacterial activity. J. Nanostructure Chem. 2014, 4, 4–9. [Google Scholar] [CrossRef]
- Wang, G.; Zhao, K.; Gao, C.; Wang, J.; Mei, Y.; Zheng, X.; Zhu, P. Green synthesis of copper nanoparticles using green coffee bean and their applications for efficient reduction of organic dyes. J. Environ. Chem. Eng. 2012, 9, 105331. [Google Scholar] [CrossRef]
- Applerot, G.; Lellouche, J.; Lipovsky, A.; Nitzan, Y.; Lubart, R.; Gedanken, A.; Banin, E. Understanding the Antibacterial Mechanism of CuO Nanoparticles: Revealing the Route of Induced Oxidative Stress. Small 2012, 8, 3326–3337. [Google Scholar] [CrossRef] [PubMed]
- Pandiyarajan, T.; Udayabhaskar, R.; Vignesh, S.; James, R.A.; Karthikeyan, B. Synthesis and concentration dependent antibacterial activities of CuO nanoflakes. Mater. Sci. Eng. C 2013, 33, 2020–2024. [Google Scholar] [CrossRef] [PubMed]
- Khalaji, A.D.; Pazhand, Z.; Kiani, K.; Machek, P.; Jarosova, M.; Mazandarani, R. CuO nanoparticles: Preparation, characterization, optical properties, and antibacterial activities. J. Mater. Sci. Mater. Electron. 2022, 31, 11949–11954. [Google Scholar] [CrossRef]
- Rajamma, R.; Nair, S.G.; Khadar, F.A.; Baskaran, B. Antibacterial and anticancer activity of biosynthesised CuO nanoparticles. IET Nanobiotechnology 2020, 14, 833–838. [Google Scholar] [CrossRef]
- Ghasemi, N.; Jamali-Sheini, F.; Zekavati, R. CuO and Ag/CuO nanoparticles: Biosynthesis and antibacterial properties. Mater. Lett. 2017, 196, 78–82. [Google Scholar] [CrossRef]
- Baek, Y.W.; An, Y.J. Microbial toxicity of metal oxide nanoparticles (CuO, NiO, ZnO, and Sb2O3) to Escherichia coli, Bacillus subtilis, and Streptococcus aureus. Sci. Total Environ. 2011, 409, 1603–1608. [Google Scholar] [CrossRef]
- Ramazanzadeh, B.; Jahanbin, A.; Yaghoubi, M.; Shahtahmassbi, N.; Ghazvini, K.; Shakeri, M.; Shafaee, H. Comparison of Antibacterial Effects of ZnO and CuO Nanoparticles Coated Brackets against Streptococcus Mutans. J. Dent. 2015, 16, 200–205. [Google Scholar]
- Ren, G.; Hu, D.; Cheng, E.W.C.; Vargas-Reus, M.A.; Reip, P.; Allaker, R.P. Characterisation of copper oxide nanoparticles for antimicrobial applications. Int. J. Antimicrob. 2009, 33, 587–590. [Google Scholar] [CrossRef]
- Das Purkayastha, M.; Manhar, A.K.; Mandal, M.; Mahanta, C.L. Industrial Waste-Derived Nanoparticles and Microspheres Can Be Potent Antimicrobial and Functional Ingredients. J. Appl. Chem. 2014, 2014, 171427. [Google Scholar] [CrossRef]
- Gonçalves, S.P.C.; Strauss, M.; Delite, F.S.; Clemente, Z.; Castro, V.L.; Martinez, D.S.T. Activated carbon from pyrolysed sugarcane bagasse: Silver nanoparticle modification and ecotoxicity assessment. Sci. Total Environ. 2016, 565, 833–840. [Google Scholar] [CrossRef] [PubMed]
- Sekaran, G.; Karthikeyan, S.; Gupta, V.K.; Boopathy, R.; Maharaja, P. Immobilization of Bacillus sp. in mesoporous activated carbon for degradation of sulphonated phenolic compound in wastewater. Mater. Sci. Eng. C Mater. Biol. Appl. 2013, 33, 735–745. [Google Scholar] [CrossRef] [PubMed]
- Saravanan, A.; Kumar, P.S.; Karthiga Devi, G.; Arumugam, T. Synthesis and characterization of metallic nanoparticles impregnated onto activated carbon using leaf extract of Mukia maderasapatna: Evaluation of antimicrobial activities. Microb. Pathog. 2016, 97, 198–203. [Google Scholar] [CrossRef]
- Devi, T.B.; Mohanta, D.; Ahmaruzzaman, M. Biomass derived activated carbon loaded silver nanoparticles: An effective nanocomposites for enhanced solar photocatalysis and antimicrobial activities. J. Ind. Eng. Chem. 2019, 76, 160–172. [Google Scholar] [CrossRef]
- Giti, R.; Zomorodian, K.; Firouzmandi, M.; Zareshahrabadi, Z.; Rahmannasab, S. Antimicrobial Activity of Thermocycled Polymethyl Methacrylate Resin Reinforced with Titanium Dioxide and Copper Oxide Nanoparticles. Int. J. Dent. 2021, 2021, 6690806. [Google Scholar] [CrossRef]
- Sathya, S.; Murthy, P.S.; Devi, V.G.; Das, A.; Anandkumar, B.; Sathyaseelan, V.; Doble, M.; Venugopalan, V. Antibacterial and cytotoxic assessment of poly (methyl methacrylate) based hybrid nanocomposites. Mater. Sci. Eng. 2019, 100, 886–896. [Google Scholar] [CrossRef]
- Glazkova, E.; Bakina, O.; Rodkevich, N.; Mosunov, A.; Evstigneev, M.; Evstigneev, V.; Klimenko, V.; Lerner, M. Antibacterial Properties of PMMA Functionalized with CuFe2O4/Cu2O/CuO Nanoparticles. Coatings 2022, 12, 957. [Google Scholar] [CrossRef]
- Varghese, S.; Kuriakose, S.; Jose, S. Antimicrobial Activity of Carbon Nanoparticles Isolated from Natural Sources against Pathogenic Gram-Negative and Gram-Positive Bacteria. J. Nanosci. 2013, 2013, 457865. [Google Scholar] [CrossRef]
- Shankar, D.; Krishnasamy, K.; Selvaraj, K. In vitro Evaluation of Antibacterial Efficacy using Passiflora foetida Activated Carbon. Res. Pharm. 2016, 6, 2986. [Google Scholar] [CrossRef][Green Version]
- Alkayal, N.S. Highly Efficient and Selective Capture of Pb(II) by New Crosslinked Melamine-Based Polymethyl Methacrylate for Water Treatment. Adsorpt. Sci. Technol. 2022, 2022, 5257960. [Google Scholar] [CrossRef]
- Balouiri, M.; Sadiki, M.; Koraichi Ibnsouda, S. Methods for in vitro evaluating antimicrobial activity: A review. J. Pharm. Anal. 2016, 6, 71–79. [Google Scholar] [CrossRef] [PubMed]
- Alghamdi, M.A.; Al-Sarraj, F.; Alamshani, W.H.; Alotibi, I.; Al-Zahrani, M.; Albiheyri, R.; Nass, N.M.; Sajer, B.H.; Bataweel, N.M.; Al-Matary, M.A.; et al. Antibacterial power of Pomegranate extracts against Beta-Lactamase producing Escherichia coli. Caryologia 2024, 77, 83–99. [Google Scholar] [CrossRef]
- ASTM E2149-20; Standard Test Method for Determining the Antimicrobial Activity of Antimicrobial Agents Under Dynamic Contact Conditions. ASTM: West Conshohocken, PA, USA, 2020.
- Nouri, F.; Yaraki, M.T.; Ghorbanpour, M.; Agarwal, S.; Gupta, V.K. Enhanced Antibacterial effect of chitosan film using Montmorillonite/CuO nanocomposite. Int. J. Biol. Macromol. 2018, 109, 1219–1231. [Google Scholar] [CrossRef]
- Siddiqui, H.; Parra, M.R.; Qureshi, M.S.; Malik, M.M.; Haque, F.Z. Studies of structural, optical, and electrical properties associated with defects in sodium-doped copper oxide (CuO/Na) nanostructures. J. Mater. 2018, 53, 8826–8843. [Google Scholar] [CrossRef]
- Salavati-Niasari, M.; Ghanbari, D. Polymeric Nanocomposite Materials; IntechOpen: London, UK, 2011. [Google Scholar]
- Elashnikov, R.; Lyutakov, O.; Ulbrich, P.; Svorcik, V. Light-activated polymethylmethacrylate nanofibers with antibacterial activity. Mater. Sci. Eng. C 2016, 64, 229–235. [Google Scholar] [CrossRef]
- Rani, G.V.; Singh, R.N. Hydrophobic coating of polymethylmetha-crylate (PMMA) on glass substrate for reduced bacterial adhesion. J. Polym. Mat. 2015, 32, 512. [Google Scholar]
- Moffa, E.B.; Malheiros, S.S.; Silva, L.T.S.; Branco, D.I.; Junior, R.C.F.G.; Brandt, W.C.; Goncalves, F.; Barao, V.A.R.; Boaro, L.C.C. Antimicrobial activity of PMMA enriched with nano-clay loaded with metronidazole and chlorhexidine. Braz. Oral Res. 2024, 38, e110. [Google Scholar] [CrossRef]
- Adaikalam, K.; Vikraman, D.; Lee, D.; Cho, Y.-A.; Kim, H.S. Optical and UV Shielding Properties of Inorganic Nanoparticles Embedded in Polymethyl Methacrylate Nanocomposite Freestanding Films. Polymers 2024, 16, 1048. [Google Scholar] [CrossRef]
- Pedroni, M.A.; Ribeiro, V.S.; Cieslinski, J.; Lopes, A.P.; Kraft, L.; Suss, P.H.; Felipe, F.F. Different concentrations of vancomycin with gentamicin loaded PMMA to inhibit biofilm formation of Staphylococcus aureus and their implications. J. Orthop. Sci. 2024, 29, 334–340. [Google Scholar] [CrossRef]

| Sample | T10 | T30 | T50 |
|---|---|---|---|
| PMMA/Mel | 305 | 311 | 326 |
| PMMA/Mel-CuO | 315 | 340 | 360 |
| PMMA/Mel-AC | 298 | 330 | 345 |
| Sample | PMMA/Mel-CuO | PMMA/Mel-AC | ||||||
|---|---|---|---|---|---|---|---|---|
| Element | C K | O K | S K | Cu L | C K | N K | O K | S K |
| Weight% | 63.69 | 28.33 | 0.51 | 7.47 | 59.34 | 20.07 | 19.99 | 0.60 |
| Atomic% | 73.58 | 24.57 | 0.22 | 1.63 | 64.66 | 18.75 | 16.35 | 0.24 |
| Polymers | Inhibition Zone (mm) | |
|---|---|---|
| E. coli | S. aureus | |
| PMMA/Mel | 9.6 | 8.3 |
| PMMA/Mel-CuO | 8.3 | 22.6 |
| PMMA/Mel-AC | 8.6 | 11.3 |
| Antibiotic | Resistance or Inhibitory Zone (mm) Produced by Antibiotics |
|---|---|
| CPM | 20 |
| GM | 15 |
| C | 4 |
| OX | R * |
| VA | |
| FC | |
| TS | 23 |
| CD | R |
| KF | |
| AP | |
| E | |
| PG | R |
| CFU | Mortality% | |
|---|---|---|
| Control | 27.33 ± 16 | - |
| PMMA/Mel | 1.6 ± 1.5 | 94% |
| PMMA/mel/CuO | 17.3 ± 18 | 37% |
| PMMA/Mel/Ac | 8.3 ± 10.11 | 70% |
Disclaimer/Publisher’s Note: The statements, opinions and data contained in all publications are solely those of the individual author(s) and contributor(s) and not of MDPI and/or the editor(s). MDPI and/or the editor(s) disclaim responsibility for any injury to people or property resulting from any ideas, methods, instructions or products referred to in the content. |
© 2025 by the authors. Licensee MDPI, Basel, Switzerland. This article is an open access article distributed under the terms and conditions of the Creative Commons Attribution (CC BY) license (https://creativecommons.org/licenses/by/4.0/).
Share and Cite
Alkayal, N.S.; Al Ghamdi, M.A. Cross-Linked Poly(methyl methacrylate) Nanocomposites’ Synthesis, Characterization, and Antibacterial Effects. Polymers 2025, 17, 269. https://doi.org/10.3390/polym17030269
Alkayal NS, Al Ghamdi MA. Cross-Linked Poly(methyl methacrylate) Nanocomposites’ Synthesis, Characterization, and Antibacterial Effects. Polymers. 2025; 17(3):269. https://doi.org/10.3390/polym17030269
Chicago/Turabian StyleAlkayal, Nazeeha S., and Mashail A. Al Ghamdi. 2025. "Cross-Linked Poly(methyl methacrylate) Nanocomposites’ Synthesis, Characterization, and Antibacterial Effects" Polymers 17, no. 3: 269. https://doi.org/10.3390/polym17030269
APA StyleAlkayal, N. S., & Al Ghamdi, M. A. (2025). Cross-Linked Poly(methyl methacrylate) Nanocomposites’ Synthesis, Characterization, and Antibacterial Effects. Polymers, 17(3), 269. https://doi.org/10.3390/polym17030269

